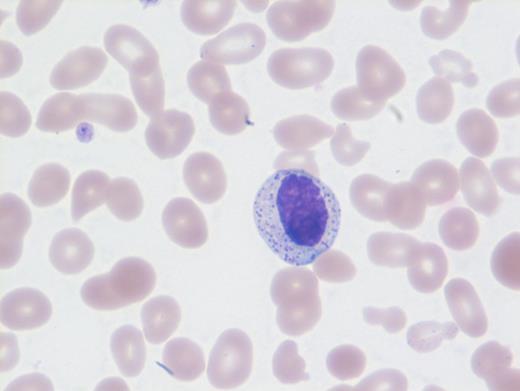
Peripheral blood, Wright stain.

A 65-year-old man presented with syncope. Imaging showed mild hepatosplenomegaly. No skin lesions were observed. Laboratory evaluation detected pancytopenia with a complete blood count showing the following:
White blood cell count 4.3 × 103/μL Hemoglobin 8.1 g/dL Platelet count 35 × 103/μL
These results prompted a subsequent bone marrow biopsy. Peripheral blood smear showed rare abnormal circulating cells (Figure 1). Bone marrow core biopsy showed clusters of spindle cells adjacent to bony trabeculae (Figure 2) that were positive for CD117 (Figure 3). Scattered teardrop cells were also noted. Molecular testing by next-generation sequencing (NGS) detected diagnostic mutations.
A. Metastatic spindle cell melanoma
B. Primary myelofibrosis
C. Systemic mastocytosis
D. Langerhans cell histiocytosis
Sorry, that was not the preferred response.
Correct!
Mast cell with metachromatic granules in circulation (Figure 1) with spindly clusters of compact mast cells in the biopsy (Figure 2) that are positive for CD117 (Figure 3) allows a diagnosis of systemic mastocytosis. These marrow spindly clusters of cells were also positive for mast cell tryptase and CD25. Mastocytosis is defined as multifocal infiltration by clonal proliferation of mast cells in one or more sites. They are broadly divided into cutaneous mastocytosis, systemic mastocytosis (SM), and mast cell sarcoma. The 2016 World Health Organization (WHO) classification of hematologic neoplasms separated them from myeloproliferative neoplasms. Cutaneous mastocytosis is restricted to the skin.
SM is defined by the presence of the major criteria and at least one minor criterion or at least three minor criteria. The major criterion consists of multifocal dense infiltrates of at least 15 mast cells in aggregate, detected in extracutaneous organ, marrow, or blood. Minor criteria can include the following: in bone marrow or extracutaneous organs, more than 25 percent of mast cells in infiltrate or aspirate with atypical spindle morphology, or that appear immature; presence of activating point mutation at codon 816 of KIT in extracutaneous organ, blood, or marrow; mast cells in blood, marrow or extracutaneous organ expressing CD25 with normal mast cell markers; and serum total tryptase persistently more than 20 ng/mL, except in cases with hematologic neoplasm.
Neoplastic mast cells often assume a spindle shape on biopsy. All mast cells co-express CD117 and mast cell tryptase. However, when they express CD25, SM should be suspected. The mast cells in this case were positive for CD117, tryptase, and CD25 (not shown).
Additionally, the marrow showed dysplastic megakaryocytes and marked marrow monocytosis (not shown) consistent with an associated myeloid neoplastic component classified as chronic myelomonocytic leukemia (CMML). Thus, the appropriate designation based on the 2017 WHO schema is “systemic mastocytosis with an associated hematologic neoplasm.”
NGS revealed mutations involving KIT (D816V), CBL, TET2, and U2AF1. Neoplastic cells in SM usually exhibit the KIT point mutation D816V. The latter three mutations are most likely attributable to CMML. This patient had rare circulating mast cells. Circulating mast cells, which are identified by the presence of numerous cytoplasmic metachromatic granules and round nuclei as noted in Figure 1 and should not be confused with myelocytes or basophils, are rare in SM. Circulating mast cells may raise the possibility of another related aggressive mast cell entity — mast cell leukemia. However, for this diagnosis, there should be at least 10 percent mast cells in peripheral blood or no less than 20 percent dispersed mast cells in bone marrow aspirate along with features of SM, neither of which were noted in this case.
Of the choices provided, only SM is positive for CD117. Langerhans cell histiocytosis usually shows some admixed eosinophils, and furthermore, they are positive for CD1a and langerin and negative for CD117. Spindle cells in melanoma metastasis are positive for S100 and SOX10 and negative for CD117. Fibrosis is usually diffuse and not patchy in primary myelofibrosis, and furthermore, these areas negative for CD117. Also, circulating mast cells would be inconsistent with primary myelofibrosis, melanoma, or Langerhans cell histiocytosis.
References
References
Dr. Venkataraman and Dr. Sir Philip indicated no relevant conflicts of interest.